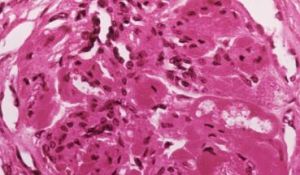
糖尿病腎衰竭

概述
糖尿病腎衰竭
糖尿病腎衰竭發病原因
糖尿病腎病(DN)是指與糖尿病代謝異常有關的腎小球硬化症,屬糖尿病全身性微血管病變範疇,是一種臨床常見的繼發性腎臟病。其臨床表現主要為蛋白尿、水腫、高血壓、高血脂、低蛋白血症、糖尿病性視網膜病變、氮質血症。
糖尿病腎衰竭是糖尿病的主要併發症之一,尤其是多年的糖尿病患者,其發病幾率會更高,少有不慎,糖尿病就會導致糖尿病腎病的發生,進而出現糖尿病腎衰。下面就讓我們來看一下糖尿病導致慢性腎衰的發病機理有哪些。
1、由於糖尿病患者血糖過高,造成腎小球的生化組成異常,引起血管的通透性增加,使血漿蛋白漏出,促使腎小球硬化的形成,糖尿病腎病出現後沒有得到及時專業的治療,從而導致糖尿病腎衰。
2、幼年糖尿病病人的血漿中生長激素的水平較高,其與過高的血糖參與糖與蛋白質的複合物的形成,因而加重了糖尿病性腎病的損害,使糖尿病腎衰竭提前進入。
3、糖尿病腎衰的發生還與糖尿病人容易繼發各種感染,如反覆發生的泌尿系嚴重的感染可以造成腎皮質壞死。糖尿病早期,由於其對腎臟的損害具有隱匿性,因此腎衰竭的症狀並不明顯,隨著病情的發展,腎小球硬化狀態變得明顯,受損的腎小球個體越來越多,越到後來發展越快,最終導致蛋白尿等症狀,使其進展為糖尿病腎衰竭。
血液透析
併發症
血液透析都會伴有不同程度的併發症,糖尿病患者尤其嚴重,以下便是糖尿病腎衰竭患者常見的血液透析併發症。1、低血壓,它的發生率約為20%,尤其是在糖尿病患者當中。可以採取碳酸氫鹽或高鈉透析液,選擇生物和溶性好的透析膜,同時套用EPO糾正貧血。
2、血透高血壓,發生幾率約為50%,約有50%的糖尿病腎衰竭患者需要抗高壓治療。可選用ccb和中樞擴血管藥物。
3、視網膜病變,約有97%的終末期患者有明顯的視網膜病變,通過控制血糖、血壓、充分透析或低分子肝素透析等方法可以減輕視網膜的病變。
4、血糖和胰島素的調節,維持性血液透析的DM患者對胰島素敏感性可升高或下降,因此其胰島素調節較困難。DM患者在透析中和透析後血糖升高,對胰島素需要量增加。引起DM透析者低血糖的原凼有透析不充分、食慾降低、進食減少;腎臟胰島素降解率下降、內源性胰島素增加;用B受體阻滯劑,干擾糖的代謝;用無糖透析液。充分透析後,對胰島素敏感性增加;DM胃輕癱可致胃排空延遲,出現餐後低血糖。
5、與血管通路有關的問題,動-靜脈瘺主要併發症有血栓、狹窄、感染、假性動脈瘤形成和高動力性心衰。少數DN終末期血液透析患者,動一靜脈瘺可導致慢性手腫、拇指疼痛綜合徵和橈動脈竊血綜合徵。
6、骨病,DN行血液透析者的骨病特點為低轉化骨病,血透幾年後,釩在骨表面沉積,最早在透析後2年即出現骨痛和骨折,因此DMESRD行血透者不應服含鋁的磷結合劑,可用活性維生索D,、鈣劑以及去鐵胺驅鋁治療。
7、營養不良的症狀很常見,要達到滿意的營養狀態,膳食總熱量應達到104.6~125.5kJ/(kg·d),其中50%的熱量來自碳水化合物。蛋白質攝人量達到1.3~15∥(kgd)。在嚴重感染或其他嚴重併發症期間,應通過胃腸內或胃腸外加強營養支持治療。用含糖透析液進行血液透析,透析液中葡萄糖含量最少達到11.1。mmovL。
8、心理和社會問題:幾乎所有的DMESRD患者都會發生一過性和(或)永久的抑鬱狀態。失明、害怕截肢、飲食和水限制的壓力均促成抑鬱狀態的發生。
方式
無論何種治療方法的選擇,都要進行相關的綜合考慮。此階段的透析方式主要有兩種即血液透析(HD)和腹膜透析(PD),由於受老年、開始透析時存在的合併症及蛋白質營養不良等因素的影響,糖尿病透析患者的死亡危險是非糖尿病透析患者的1.5倍,因此,在透析方法的選擇上應當謹慎。血液透析在美國、日本等國家是糖尿病終末期腎衰竭患者最長選擇的方式。它的特點是高效率。能夠在短時間內(4-5h)有效地清除毒素及體內過多的水分,糾正電解質和酸鹼平衡紊亂,在透析過程中會丟失一些胺基酸和肽類,蛋白質丟失量較少,同時它還便於經常隨訪。但是,容易使患者出現低血糖、高鉀血症、低血壓和血管道路功能不良等症狀。
腹膜透析則具有易於糾正貧血、液體控制度和血壓控制度較好、腕管綜合徵發生少、有益於殘餘腎功能的保護、可在腹腔內注射胰島素和不依賴機器等優點,但同時也有加重胃癱瘓、腹膜炎的危險等不利因素。
沒有隨機的進行相關比較在兩種透析方式中糖尿病患者的存活率。於HD相比,患者小於45歲進行PD有更高的存活率和更少的合併症,尤其是開始透析時無心臟病和不吸菸的患者;年齡較大的(大於60歲)患者,以HD較好。
終末期
糖尿病終末期腎衰竭患者開始透析的時機要比非糖尿病所致者早一些,當肌酐清除率(CCr)為10-15ml/min時,便應該開始,如果尿毒症症狀明顯,CCr為15-20ml/min時就應該開始透析治療。因為糖尿病患者一旦出現腎功能不全,經常進展迅速,常見的現象便是當患者還處在腎病綜合徵階段,其CCr已經開始下降,在腎功能損害並非很嚴重時,則可出現明顯的尿毒症症狀和難以控制的水鈉瀦留,它與患者存在的其它糖尿病併發症如心血管病變、胃腸道病變等和低白蛋白血症、營養不良有著密切的關係。同時,當CCr小於10-15ml/min時,則不易控制血壓,可加速糖尿病的視網膜病變、加重心臟、腦血管病變等。如果及早治療,不僅可以有效緩解腎臟方面的眾多問題,還可以較好的糾正營養不良狀況,更好的保持殘存的視力。
預防方法
1.嚴格控制血糖及乾體重。因為長期高血糖狀態及肥胖是糖尿病腎病發病的最主要因素,也是預防的關鍵。2.飲食上:控制鹽及油的攝入。每日植物油20~30ml;補充維生素、葉酸及礦物質。應限制磷的攝入量在800mg/天以下;蛋白質的攝入,早期糖尿病患者可不限制蛋白質的量,而一旦進入腎衰竭下降到60ml以下或有蛋白尿則應限制蛋白質的攝入量,否則會加重腎臟損害。這時蛋白質每日攝入量應低於0.8g/kg,並儘量選擇優質低蛋白質(魚、肉、蛋類)採取限制保質的原則。
3.慎選口服降糖藥。儘量選擇對腎臟毒性小的藥物。
4.胰島素治療。對於口服藥控制不好或已有腎功能損害的患者應儘早使用胰島素。
5.若合併高血壓須降壓治療。
6.定期進行血糖及尿蛋白的檢測,一旦發現蛋白尿應儘快找出相關醫生診治。
7.糖尿病患者要每天在家人或者護士的帶同下適當的做身體鍛鍊,不易過勞,要保持好的心情。
飲食治療
當尿中出現微量蛋白時,即是腎功能損傷的最早信號,就要開始保護腎功能、減輕腎臟負擔的各種措施,以防腎功能損害的加重。飲食治療的重點是控制血糖、調整蛋白質攝入量和質。糖尿病腎病腎功能衰竭飲食原則:
⒈熱量要充足:適當增多糖類的攝入,以保證每日每千克體重30~40千卡的熱量攝人。飲食方面可適當多吃山藥、土豆、冬粉、粉條、藕粉,甚至水果、蔗糖、麥芽糖等。
⒉優質低蛋白飲食:應限制蛋白質攝人總量1期2期病人蛋白質總攝人每日應控制在30~40克,4期病人控制在30克以下,5期病人則應控制在25克甚至20克以下。應適當增多優質蛋白在蛋白質攝人總量中所占比例,可多吃牛奶、雞蛋白等動物蛋白,減少植物蛋白攝人,可少吃主食,禁食豆類食品及其製品。
⒊高鈣低磷飲食:限制高磷食品,禁用動物內臟及南瓜子等乾果,適當加用含鈣高的食品,如海帶絲、綠色蔬菜等。動物蛋白如瘦肉等含磷較高。可通過先煮肉,棄汁炒肉的辦法,減少磷的攝人。低脂高纖維高維生素飲食禁食動物油,儘量少吃肥肉,多吃玉米面、蕎麥麵等粗糧、甘薯、芋頭、海帶絲、蔬菜等高纖維素和高維生素食品,血糖控制好者,也可吃桃、梨、橘、柚、橙、蘋果等水果。
檢查
(一)尿糖定性是篩選糖尿病的一種簡易方法,但在糖尿病腎病可出現假陰性或假陽性,故測定血糖是診斷的主要依據。
(二)尿白蛋白排泄率(UAE)20~200μgmin,是診斷早期糖尿病腎病的重要指標;當UAE持續大於200μgmin或常規檢查尿蛋白陽性(尿蛋白定量大於0.5g24h),即診斷為糖尿病腎病。尿沉渣一般改變不明顯,較多白細胞時提示尿路感染;有大量紅細胞,提示可能有其他原因所致的血尿。
(三)糖尿病腎病晚期,內生肌酐清除率下降和血尿素氮、肌酐增高。
(四)核素腎動態腎小球濾過率(GFR)增加和B超測量腎體積增大,符合早期糖尿病腎病。在尿毒症時GFR明顯下降,但腎臟體積往往無明顯縮小。
(五)眼底檢查,必要時作螢光眼底造影,可見微動脈瘤等糖尿病眼底病變。
病分期
糖尿病腎病的分期主要包括五個見如下:
Ⅰ期:這一期主要的以腎小球濾過率增高和腎體積增大為特徵。這種初期的病變與患有高血糖的水平是一致的,但是可逆的,經過醫院給予的胰島素治療可以得以恢復,但是專家解釋會所不一定能完全的恢復到正常的狀態。
Ⅱ期:該期患者的尿白蛋白排出率已呈現正常但腎小球已出現結構上的改變。這期腎臟內尿白蛋白排出率(UAE)正常(<20μg/min或<30mg/24h),運動後UAE增高組可恢復。腎小球毛細血管基底膜(GBM)開始增厚,系膜基質開始增加,GFR多高於正常範圍並與血糖水平呈現一致,GFR>150mL/min患者的糖化血紅蛋白常>9.5%。GFR>150mL/min和UAE>30μg/min的病人更易發展為糖尿病腎病的可能很大。
Ⅲ期:此期又被叫做是早期糖尿病腎病。患者腎臟尿白蛋白排出率為20~200μg/min,病人的血壓出現輕度的升高趨勢,開始出現腎小球的功能減退。
Ⅳ期:是臨床上的糖尿病腎病或顯性的糖尿病腎病。這一期的特點是患者開始出現大量的白蛋白尿(每日大於3.5克),水腫和高血壓。糖尿病腎病患者的水腫開始變得比較嚴重,對利尿藥反應差。
Ⅴ期:即為終末期腎功能衰竭期。糖尿病病人一旦出現持續性尿蛋白就有可能發展為糖尿病腎病,由於腎小球基膜廣泛增厚,腎小球毛細血管腔進行性狹窄和更多的腎小球壞退,腎臟濾過功能進行性下降,導致腎功能衰竭。

